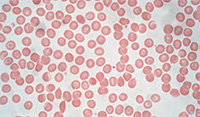
Erthrocytes (blood cells) captured under a hematology microscope. Erthrocytes (blood cells) captured under a hematology microscope.

Choosing a Hematology Microscope
Posted by Microscope World on Sep 26th 2022
Hematology microscopes are used to study, diagnose, treat and prevent diseases related to blood and its components such as blood cells, hemoglobin, blood proteins and coagulation of the blood. Blood and bone marrow are viewed under a hematology microscope.
Hematology is the study of blood and blood disorders. Hematologists analyze blood smears under the microscope to look for abnormalities in the blood indicative of disease. In order to accurately analyze blood samples, hematologists require microscopes that provide a clear image of each sample and high color fidelity. Additionally, having a high-quality camera attached to the microscope allows for accurate digital documentation of each sample. There are several microscopes that have been configured specifically for viewing hematology samples, including the RB41 Hematology Lab Microscope.
When examining a peripheral blood smear, a hematologist starts with a low magnification objective such as a 10x or 20x lens. The hematologist is looking for an overview of red and white blood cell densities, the number of erythrocytes (shown at left) present, the color and rough morphology, and if obvious cellular inclusions are present. In higher magnification of typically 60x or 100x, (sometimes 40x for bone marrow), a manual differential cell count is performed and red and white blood cell morphology including the presence of inclusions or parasites are assessed.
When examining a peripheral blood smear, a hematologist starts with a low magnification objective such as a 10x or 20x lens. The hematologist is looking for an overview of red and white blood cell densities, the number of erythrocytes (shown at left) present, the color and rough morphology, and if obvious cellular inclusions are present. In higher magnification of typically 60x or 100x, (sometimes 40x for bone marrow), a manual differential cell count is performed and red and white blood cell morphology including the presence of inclusions or parasites are assessed.
What to look for when selecting a Hematology Microscope:
- High Quality Microscope Optics
Hematology requires a very good differentiation of cell types and clearly visible cellular details. Hematologists rely on crystal-clear images to visualize morphological details such as delicate granules, Auer rods, irregularities of the nuclear membrane or clefted nuclei.
- Decide if Ergonomics are Important
Are ergonomics important? If many hours are spent viewing samples, an ergonomic viewing head is best. The Fein Optic RB41 Hematology Microscope has an ergonomic option available. - Are Digital Images Required?
There are many options for setting up digital microscopy. If your budget doesn't currently allow for a digital hematology microscope, but you may wish to add it in the future, purchase a trinocular head that has a camera port. This will give the option to upgrade to include a camera down the road. The RB41 hematology microscope has the option to attach a camera for image capture and is available with a standard viewing head or ergonomic viewing head.
Have questions about which microscope is right for you? Contact Microscope World at 800-942-0528.





